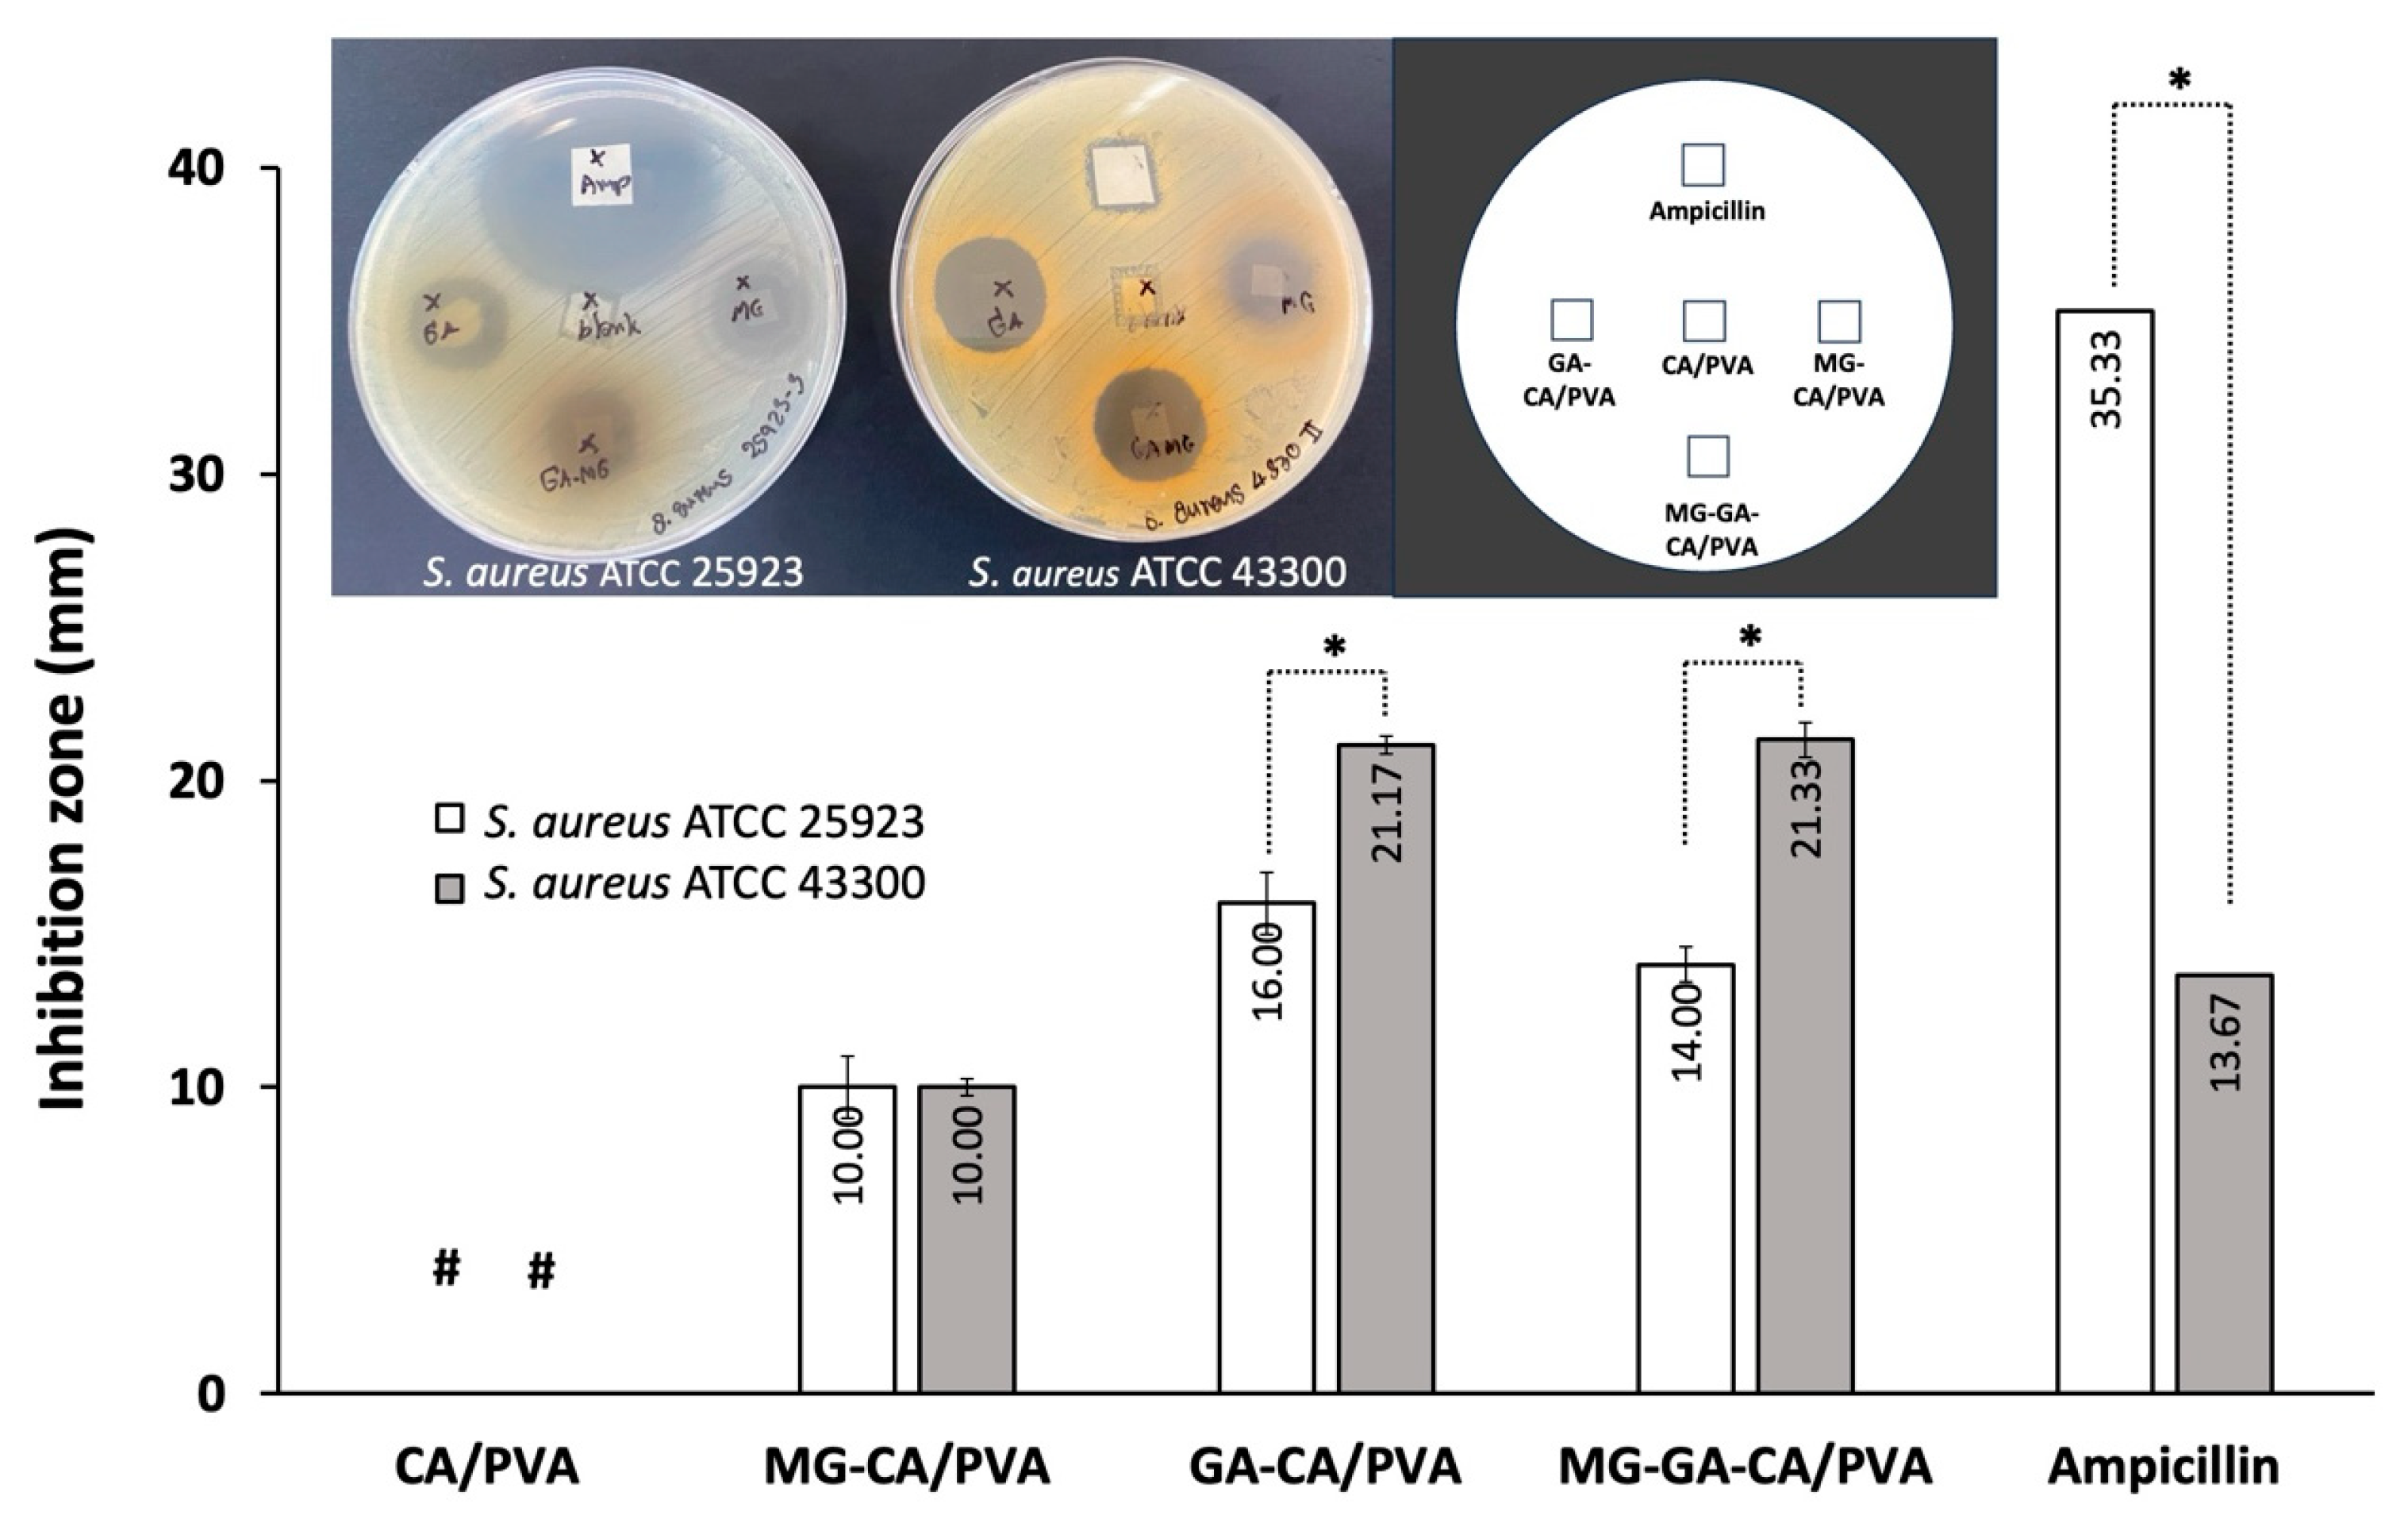
Polymers 16 02971 g009

Electrospun Cellulose Acetate/Poly(Vinyl Alcohol) Nanofibers Loaded with Methyl Gallate and Gallic Acid for Anti-Staphylococcus aureus Applications
Abstract
1. Introduction
2. Materials and Methods
2.1. Materials
2.2. Electrospinning of CA/PVA Nanofibers
2.3. Characterizations
2.3.1. Physical, Chemical, Thermal, and Mechanical Properties
2.3.2. Contact Angle Analysis
2.3.3. Swelling Test
2.3.4. Release Test
2.4. Anti-S. aureus Activity Test
2.5. Statistical Analysis
3. Results and Discussion
3.1. Optimization of Electrospinning Conditions
3.2. Characterization of Electrospun Fiber Mats Loaded with Phenolic Compounds
3.2.1. SEM
3.2.2. FTIR
3.2.3. DSC
3.3. Tensile Strength
3.4. Contact Angle
3.5. Swelling Behavior
3.6. Release Behavior
3.7. Anti-S. aureus Activity
4. Conclusions
Author Contributions
Funding
Institutional Review Board Statement
Data Availability Statement
Acknowledgments
Conflicts of Interest
References
- Choubey, S.; Varughese, L.R.; Kumar, V.; Beniwal, V. Medicinal importance of gallic acid and its ester derivatives: A patent review. Pharm. Pat. Anal. 2015, 4, 305–315. [Google Scholar] [CrossRef] [PubMed]
- Shojaee, M.S.; Moeenfard, M.; Farhoosh, R. Kinetics and stoichiometry of gallic acid and methyl gallate in scavenging DPPH radical as affected by the reaction solvent. Sci. Rep. 2022, 12, 8765. [Google Scholar] [CrossRef] [PubMed]
- Kahkeshani, N.; Farzaei, F.; Fotouhi, M.; Alavi, S.S.; Bahramsoltani, R.; Naseri, R.; Momtaz, S.; Abbasabadi, Z.; Rahimi, R.; Farzaei, M.H. Pharmacological effects of gallic acid in health and diseases: A mechanistic review. Iran. J. Basic Med. Sci. 2019, 22, 225. [Google Scholar] [PubMed]
- Ng, T.B.; Wong, J.H.; Tam, C.; Liu, F.; Cheung, C.F.; Ng, C.C.; Tse, R.; Tak, F.T.; Chan, H. Methyl gallate as an antioxidant and anti-HIV agent. In HIV/AIDS; Academic Press: Cambridge, MA, USA, 2018; pp. 161–168. [Google Scholar]
- Keyvani-Ghamsari, S.; Rahimi, M.; Khorsandi, K. An update on the potential mechanism of gallic acid as an antibacterial and anticancer agent. Food Sci. Nutr. 2023, 11, 5856–5872. [Google Scholar] [CrossRef] [PubMed]
- Liang, H.; Huang, Q.; Zou, L.; Wei, P.; Lu, J.; Zhang, Y. Methyl gallate: Review of pharmacological activity. Pharmacol. Res. 2023, 194, 106849. [Google Scholar] [CrossRef]
- Tian, Q.; Wei, S.; Su, H.; Zheng, S.; Xu, S.; Liu, M.; Bo, R.; Li, J. Bactericidal activity of gallic acid against multi-drug resistance Escherichia coli. Microb. Pathog. 2022, 173, 105824. [Google Scholar] [CrossRef]
- Naga, N.G.; Zaki, A.A.; El-Badan, D.E.; Rateb, H.S.; Ghanem, K.M.; Shaaban, M.I. Inhibition of Pseudomonas aeruginosa quorum sensing by methyl gallate from Mangifera indica. Sci. Rep. 2023, 13, 17942. [Google Scholar] [CrossRef]
- Gobin, M.; Proust, R.; Lack, S.; Duciel, L.; Des Courtils, C.; Pauthe, E.; Gand, A.; Seyer, D. A Combination of the natural molecules gallic acid and carvacrol eradicates P. aeruginosa and S. aureus mature biofilms. Int. J. Mol. Sci. 2022, 23, 7118. [Google Scholar] [CrossRef] [PubMed]
- Flores-Maldonado, O.; Lezcano-Domínguez, C.I.; Dávila-Aviña, J.; González, G.M.; Ríos-López, A.L. Methyl gallate attenuates virulence and decreases antibiotic resistance in extensively drug-resistant Pseudomonas aeruginosa. Microb. Pathog. 2024, 194, 106830. [Google Scholar] [CrossRef]
- Jiamboonsri, P.; Eurtivong, C.; Wanwong, S. Assessing the potential of gallic acid and methyl gallate to enhance the efficacy of β-lactam antibiotics against methicillin-resistant Staphylococcus aureus by targeting β-Lactamase: In silico and in vitro studies. Antibiotics 2023, 12, 1622. [Google Scholar] [CrossRef]
- Rayan, M.; Abu Lafi, S.; Falah, M.; Kacergius, T.; Kirkliauskiene, A.; Gabe, V.; Rayan, A. Alkyl gallates as potential antibiofilm agents: A review. Molecules 2023, 28, 1751. [Google Scholar] [CrossRef] [PubMed]
- Sang, H.; Jin, H.; Song, P.; Xu, W.; Wang, F. Gallic acid exerts antibiofilm activity by inhibiting methicillin-resistant Staphylococcus aureus adhesion. Sci. Rep. 2024, 14, 17220. [Google Scholar] [CrossRef] [PubMed]
- Jiamboonsri, P.; Pithayanukul, P.; Bavovada, R.; Chomnawang, M.T. The inhibitory potential of Thai mango seed kernel extract against methicillin-resistant Staphylococcus aureus. Molecules 2011, 16, 6255–6270. [Google Scholar] [CrossRef] [PubMed]
- Jiamboonsri, P.; Pithayanukul, P.; Bavovada, R.; Leanpolchareanchai, J.; Yin, T.; Gao, S.; Hu, M. Factors influencing oral bioavailability of Thai mango seed kernel extract and its key phenolic principles. Molecules 2015, 20, 21254–21273. [Google Scholar] [CrossRef]
- Jiamboonsri, P.; Pithayanukul, P.; Bavovada, R.; Leanpolchareanchai, J.; Gao, S.; Hu, M. In vitro glucuronidation of methyl gallate and pentagalloyl glucopyranose by liver microsomes. Drug Metab. Pharmacokinet. 2016, 31, 292–303. [Google Scholar] [CrossRef]
- Luraghi, A.; Peri, F.; Moroni, L. Electrospinning for drug delivery applications: A review. J. Control. Release 2021, 334, 463–484. [Google Scholar] [CrossRef] [PubMed]
- Gürtler, A.-L.; Rades, T.; Heinz, A. Electrospun fibers for the treatment of skin diseases. J. Control. Release 2023, 363, 621–640. [Google Scholar] [CrossRef]
- Li, H.; Chen, X.; Lu, W.; Wang, J.; Xu, Y.; Guo, Y. Application of electrospinning in antibacterial field. Nanomaterials 2021, 11, 1822. [Google Scholar] [CrossRef]
- Liu, H.; Bai, Y.; Huang, C.; Wang, Y.; Ji, Y.; Du, Y.; Xu, L.; Yu, D.-G.; Bligh, S.W.A. Recent progress of electrospun herbal medicine nanofibers. Biomolecules 2023, 13, 184. [Google Scholar] [CrossRef]
- Liao, Q.; Kim, E.J.; Tang, Y.; Xu, H.; Yu, D.G.; Song, W.; Kim, B.J. Rational design of hyper-crosslinked polymers for biomedical applications. J. Polym. Sci. 2024, 62, 1517–1535. [Google Scholar] [CrossRef]
- Fathi, H.A.; Abdelkader, A.; AbdelKarim, M.S.; Abdelaziz, A.A.; El-Mokhtar, M.A.; Allam, A.; Fetih, G.; El Badry, M.; Elsabahy, M. Electrospun vancomycin-loaded nanofibers for management of methicillin-resistant Staphylococcus aureus-induced skin infections. Int. J. Pharm. 2020, 586, 119620. [Google Scholar] [CrossRef] [PubMed]
- Fahimirad, S.; Satei, P.; Ganji, A.; Abtahi, H. Wound healing capability of the double-layer polycaprolactone/polyvinyl alcohol-chitosan lactate electrospun nanofiber incorporating Echinacea purpurea extract. J. Drug Deliv. Sci. Technol. 2023, 87, 104734. [Google Scholar] [CrossRef]
- Li, B.; Yang, X. Rutin-loaded cellulose acetate/poly(ethylene oxide) fiber membrane fabricated by electrospinning: A bioactive material. Mater. Sci. Eng. C 2020, 109, 110601. [Google Scholar] [CrossRef]
- Türkoğlu, G.C.; Khomarloo, N.; Mohsenzadeh, E.; Gospodinova, D.N.; Neznakomova, M.; Salaün, F. PVA-based electrospun materials—A promising route to designing nanofiber mats with desired morphological shape—A review. Int. J. Mol. Sci. 2024, 25, 1668. [Google Scholar] [CrossRef]
- Khoshnevisan, K.; Maleki, H.; Samadian, H.; Shahsavari, S.; Sarrafzadeh, M.H.; Larijani, B.; Dorkoosh, F.A.; Haghpanah, V.; Khorramizadeh, M.R. Cellulose acetate electrospun nanofibers for drug delivery systems: Applications and recent advances. Carbohydr. Polym. 2018, 198, 131–141. [Google Scholar] [CrossRef]
- ASTM D638-10; Standard Test Method for Tensile Properties of Plastics. ASTM: West Conshohocken, PA, USA, 2015.
- SalehHudin, H.S.; Mohamad, E.N.; Mahadi, W.N.L.; Muhammad Afifi, A. Multiple-jet electrospinning methods for nanofiber processing: A review. Mater. Manuf. Process. 2018, 33, 479–498. [Google Scholar] [CrossRef]
- Angel, N.; Guo, L.; Yan, F.; Wang, H.; Kong, L. Effect of processing parameters on the electrospinning of cellulose acetate studied by response surface methodology. J. Agric. Food Res. 2020, 2, 100015. [Google Scholar] [CrossRef]
- Teixeira, M.; Amorim, M.; Felgueiras, H. PVA/CA based electrospun nanofibers: Influence of processing parameters in the fiber diameter. IOP Conf. Ser. Mater. Sci. Eng. 2019, 634, 012040. [Google Scholar] [CrossRef]
- Al-Abduljabbar, A.; Farooq, I. Electrospun polymer nanofibers: Processing, properties, and applications. Polymers 2023, 15, 65. [Google Scholar] [CrossRef]
- De Schoenmaker, B.; Van der Schueren, L.; Ceylan, Ö.; De Clerck, K. Electrospun polyamide 4.6 nanofibrous nonwovens: Parameter study and characterization. J. Nanomater. 2012, 2012, 860654. [Google Scholar] [CrossRef]
- Kerwald, J.; de Moura Junior, C.F.; Freitas, E.D.; de Moraes Segundo, J.d.D.P.; Vieira, R.S.; Beppu, M.M. Cellulose-based electrospun nanofibers: A review. Cellulose 2022, 29, 25–54. [Google Scholar] [CrossRef]
- Wutticharoenmongkol, P.; Hannirojram, P.; Nuthong, P. Gallic acid-loaded electrospun cellulose acetate nanofibers as potential wound dressing materials. Polym. Adv. Technol. 2019, 30, 1135–1147. [Google Scholar] [CrossRef]
- Chuysinuan, P.; Thanyacharoen, T.; Techasakul, S.; Ummartyotin, S. Electrospun characteristics of gallic acid-loaded poly vinyl alcohol fibers: Release characteristics and antioxidant properties. J. Sci. Adv. Mater. Dev. 2018, 3, 175–180. [Google Scholar] [CrossRef]
- Sukchai, P.; Wanwong, S.; Wootthikanokkhan, J. Electrospun cellulose air filter coated with zeolitic imidazolate frameworks (ZIFs) for efficient particulate matter removal: Effect of coated ZIFs on filtration performance. Fibers Polym. 2022, 23, 1206–1216. [Google Scholar] [CrossRef]
- Prakashkumar, N.; Sivamaruthi, B.S.; Chaiyasut, C.; Suganthy, N. Decoding the neuroprotective potential of methyl gallate-loaded starch nanoparticles against beta amyloid-induced oxidative stress-mediated apoptosis: An in vitro study. Pharmaceutics 2021, 13, 299. [Google Scholar] [CrossRef]
- Ji, Y.; Liang, N.; Xu, J.; Zuo, D.; Chen, D.; Zhang, H. Cellulose and poly (vinyl alcohol) composite gels as separators for quasi-solid-state electric double layer capacitors. Cellulose 2019, 26, 1055–1065. [Google Scholar] [CrossRef]
- Tsioptsias, C.; Fardis, D.; Ntampou, X.; Tsivintzelis, I.; Panayiotou, C. Thermal behavior of poly (vinyl alcohol) in the form of physically crosslinked film. Polymers 2023, 15, 1843. [Google Scholar] [CrossRef]
- Van Der Sman, R. Predictions of glass transition temperature for hydrogen bonding biomaterials. J. Phys. Chem. B 2013, 117, 16303–16313. [Google Scholar] [CrossRef]
- Wittenberg, E.; Meyer, A.; Eggers, S.; Abetz, V. Hydrogen bonding and thermoplastic elastomers—A nice couple with temperature-adjustable mechanical properties. Soft Matter 2018, 14, 2701–2711. [Google Scholar] [CrossRef]
- Chowdhury, S.C.; Gillespie Jr, J.W. A molecular dynamics study of the effects of hydrogen bonds on mechanical properties of Kevlar® crystal. Comput. Mater. Sci. 2018, 148, 286–300. [Google Scholar] [CrossRef]
- Luo, J.; Zuo, D.; Deng, Z.; Ji, A.; Xia, G. Effects of heat treatment and tea polyphenols on the structure and properties of polyvinyl alcohol nanofiber films for food packaging. Coatings 2020, 10, 49. [Google Scholar] [CrossRef]
- Förch, R.; Schönherr, H.; Jenkins, A.T.A. (Eds.) Appendix C: Contact Angle Goniometry. In Surface Design: Applications in Bioscience and Nanotechnology; Wiley-VCH Verlag GmbH & Co. KGaA: Weinheim, Germany, 2009; pp. 471–473. [Google Scholar]
- Luzi, F.; Puglia, D.; Dominici, F.; Fortunati, E.; Giovanale, G.; Balestra, G.M.; Torre, L. Effect of gallic acid and umbelliferone on thermal, mechanical, antioxidant and antimicrobial properties of poly (vinyl alcohol-co-ethylene) films. Polym. Degrad. Stab. 2018, 152, 162–176. [Google Scholar] [CrossRef]
- Andrade, J.; González-Martínez, C.; Chiralt, A. Effect of phenolic acids on the properties of films from Poly (vinyl alcohol) of different molecular characteristics. Food Packag. Shelf Life 2021, 29, 100711. [Google Scholar] [CrossRef]
- Bersanetti, P.A.; Escobar, V.H.; Nogueira, R.F.; Ortega, F.d.S.; Schor, P.; Morandim-Giannetti, A.d.A. Enzymatically obtaining hydrogels of PVA crosslinked with ferulic acid in the presence of laccase for biomedical applications. Eur. Polym. J. 2019, 112, 610–618. [Google Scholar] [CrossRef]
- Supaphol, P.; Chuangchote, S. On the electrospinning of poly(vinyl alcohol) nanofiber mats: A revisit. J. Appl. Polym. Sci. 2008, 108, 969–978. [Google Scholar] [CrossRef]
- Li, Y.; Yao, S. High stability under extreme condition of the poly (vinyl alcohol) nanofibers crosslinked by glutaraldehyde in organic medium. Polym. Degrad. Stab. 2017, 137, 229–237. [Google Scholar] [CrossRef]
- Youdhestar; Mahar, F.K.; Das, G.; Tajammul, A.; Ahmed, F.; Khatri, M.; Khan, S.; Khatri, Z. Fabrication of ceftriaxone-loaded cellulose acetate and polyvinyl alcohol nanofibers and their antibacterial evaluation. Antibiotics 2022, 11, 352. [Google Scholar] [CrossRef]

| Compounds | Concentrations (mg/mL) | ||
|---|---|---|---|
| MG-CA/PVA | GA-CA/PVA | MG-GA-CA/PVA | |
| PVA | 90 | 90 | 90 |
| CA | 10 | 10 | 10 |
| MG | 7.5 | - | 7.5 |
| GA | - | 0.9 | 0.9 |
Disclaimer/Publisher’s Note: The statements, opinions and data contained in all publications are solely those of the individual author(s) and contributor(s) and not of MDPI and/or the editor(s). MDPI and/or the editor(s) disclaim responsibility for any injury to people or property resulting from any ideas, methods, instructions or products referred to in the content. |
© 2024 by the authors. Licensee MDPI, Basel, Switzerland. This article is an open access article distributed under the terms and conditions of the Creative Commons Attribution (CC BY) license (https://creativecommons.org/licenses/by/4.0/).
Share and Cite
Jiamboonsri, P.; Sangkhun, W.; Wanwong, S. Electrospun Cellulose Acetate/Poly(Vinyl Alcohol) Nanofibers Loaded with Methyl Gallate and Gallic Acid for Anti-Staphylococcus aureus Applications. Polymers 2024, 16, 2971. https://doi.org/10.3390/polym16212971
Jiamboonsri P, Sangkhun W, Wanwong S. Electrospun Cellulose Acetate/Poly(Vinyl Alcohol) Nanofibers Loaded with Methyl Gallate and Gallic Acid for Anti-Staphylococcus aureus Applications. Polymers. 2024; 16(21):2971. https://doi.org/10.3390/polym16212971
Chicago/Turabian StyleJiamboonsri, Pimsumon, Weradesh Sangkhun, and Sompit Wanwong. 2024. "Electrospun Cellulose Acetate/Poly(Vinyl Alcohol) Nanofibers Loaded with Methyl Gallate and Gallic Acid for Anti-Staphylococcus aureus Applications" Polymers 16, no. 21: 2971. https://doi.org/10.3390/polym16212971
APA StyleJiamboonsri, P., Sangkhun, W., & Wanwong, S. (2024). Electrospun Cellulose Acetate/Poly(Vinyl Alcohol) Nanofibers Loaded with Methyl Gallate and Gallic Acid for Anti-Staphylococcus aureus Applications. Polymers, 16(21), 2971. https://doi.org/10.3390/polym16212971






